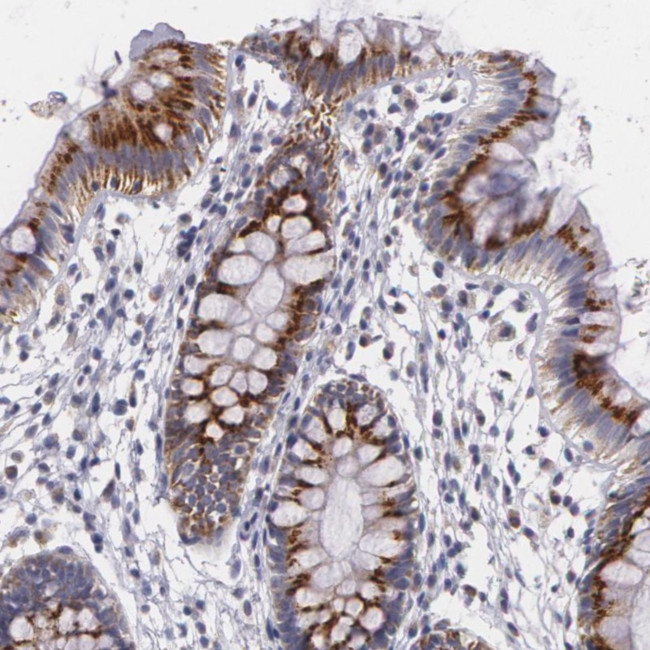
ICK Antibody in Immunohistochemistry (Paraffin) (IHC (P))

Search
Invitrogen
ICK Polyclonal Antibody
{{$productOrderCtrl.translations['antibody.pdp.commerceCard.promotion.promotions']}}
{{$productOrderCtrl.translations['antibody.pdp.commerceCard.promotion.viewpromo']}}
{{$productOrderCtrl.translations['antibody.pdp.commerceCard.promotion.promocode']}}: {{promo.promoCode}} {{promo.promoTitle}} {{promo.promoDescription}}. {{$productOrderCtrl.translations['antibody.pdp.commerceCard.promotion.learnmore']}}
产品信息
PA5-51513
种属反应
宿主/亚型
分类
类型
抗原
偶联物
形式
浓度
规格
纯化类型
保存液
内含物
保存条件
运输条件
RRID
产品详细信息
Immunogen sequence: VGHPLGSTTQ NLQDSEKPQK GILEKAGPPP YIKPVPPAQP PAKPHTRISS RQHQASQPPL HLTYPYKAEV SRTDHPSHLQ EDKPSPLLFP SLHNKHPQSK ITAGLEHKNG EIKPKSRRR
Highest antigen sequence identity to the following orthologs: Mouse - 66%, Rat - 63%.
靶标信息
ICK or intestinal cell kinase belongs to a very extensive family of proteins that share a conserved catalytic core common with both serine/threonine and tyrosine protein kinases. ICK encodes an intestinal serine/threonine kinase harboring a dual phosphorylation site found in mitogen-activating protein (MAP) kinases. ICK localizes to the intestinal crypt region and is thought to be important in intestinal epithelial cell proliferation and differentiation. ICK purified from transfected human embryonic kidney cells undergoes autophosphorylation and phosphorylates a test protein. ICK plays a key role in development of central nervous, skeletal, and endocrine systems.
仅用于科研。不用于诊断过程。未经明确授权不得转售。
篇参考文献 (0)
生物信息学
蛋白别名: Ciliogenesis associated kinase 1; hICK; iciliogenesis associated kinase 1; intestinal cell (MAK-like) kinase; Intestinal cell kinase; Laryngeal cancer kinase 2; LCK2; MAK-related kinase; MRK; MRK; protein kinase; serine/threonine protein kinase; Serine/threonine-protein kinase ICK; unnamed protein product
基因别名: CILK1; ECO; EJM10; hICK; ICK; KIAA0936; LCK2; MRK
UniProt ID: (Human) Q9UPZ9
Entrez Gene ID: (Human) 22858